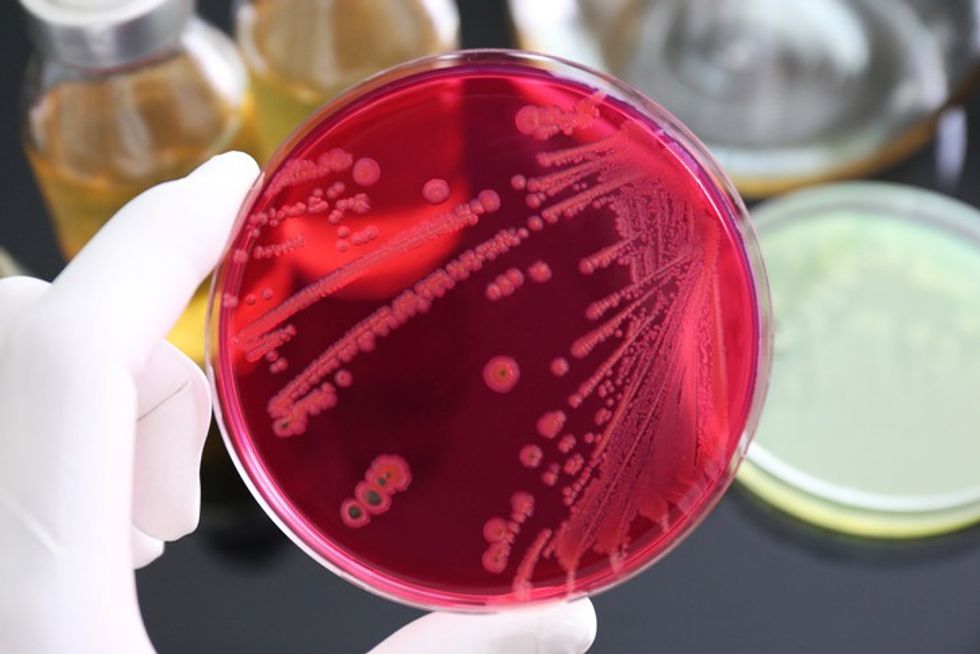
salmonella bacteria in petri dish 2

Ditët e ngrohta po vijnë dhe rreziku i salmonelës: Një bakter që shkakton diarre dhe të vjella

Salmonela është një nga bakteret më të zakonshme që sulmon trupin, zakonisht traktin tretës
Ky bakter e mori emrin e shkencëtarit amerikan dr. Salmon. Infeksioni, i shkaktuar nga salmonela, quhet salmonelozë dhe çdokush mund ta marrë atë, veçanërisht njerëzit që po luftojnë me një sëmundje të rëndë.
Kjo sëmundje me origjinë nga kafshët, gjen përhapje më të gjerë në stinën e verës, për faktin se mikrobet kanë predispozitë të shumohen më tepër, transmeton Telegrafi.
Simptomat
Salmonela mund të shfaqet 12 deri në 72 orë pas infektimit me bakterin dhe jo të gjithë kanë simptoma.
Simptomat e para përfshijnë:
- diarre
- temperaturë
- të vjella
- ngërçe në stomak.
Simptomat zgjasin nga katër deri në shtatë ditë dhe pacientët zakonisht nuk kanë nevojë të shtrohen në spital.
E vetmja gjë që mund të jetë e rrezikshme është nëse ndodh dehidrimi, për shkak të rraskapitjes së organizmit, prandaj rekomandohet marrja e shpeshtë e lëngjeve.
Salmonela zakonisht përhapet në ushqime të kontaminuara që nuk përgatiten siç duhet para ngrënies. Bakteret jetojnë te kafshët shtëpiake dhe më së shpeshti mund të gjenden në vezë ose duke ngrënë mish të papjekur ose të skuqur.
Këshillë: Për t'u siguruar që të vrisni të gjitha bakteret, sigurohuni që ta gatuani mirë mishin. Gjithashtu, frutat dhe perimet duhet të lahen mirë përpara se të hahen ose përgatiten. Salmonela ka të bëjë edhe me higjienën, ndaj nëse nuk i lani duart pas përdorimit të tualetit dhe filloni të përgatisni ushqimin, mund të merrni edhe këtë bakter.
Zakonisht nuk është kërcënuese për jetën dhe më pak se një për qind e njerëzve vdesin nga efektet e këtij bakteri. Sidomos nëse ndodhin komplikime të caktuara.
Me diarre dhe të vjella, ekziston rreziku i dehidrimit, ndaj është shumë e rëndësishme të pini shumë lëngje. Nëse salmonela hyn në qarkullimin e gjakut, ajo mund të infektojë indet në trupin tuaj, duke përfshirë trurin, zemrën dhe enët e gjakut.
Disa njerëz mund të fitojnë artrit reaktiv, i njohur gjithashtu si sindroma e Reiter, edhe disa muaj pasi janë infektuar me bakterin. Kjo shkakton dhimbje kyçesh, acarim të syve dhe urinim të dhimbshëm.
Nëse keni ndonjë nga këto simptoma, e ndjekur nga një temperaturë që zgjat më shumë se një ditë ose nuk ulet, ose nëse simptomat zgjasin më shumë se tre ditë, sigurohuni që të telefononi mjekun tuaj. /Telegrafi/